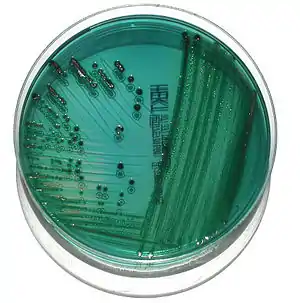

Gélose Hektoen
La gélose Hektoen est un milieu de culture servant à isoler les Salmonella, Shigella, Yersinia.
Composition
- protéose-peptone :..........................................12,0 g
- extrait de levure : facteur de croissance..................3,0 g
- lactose : critère de différenciation.......................12,0 g
- saccharose : critère de différenciation....................12,0 g
- salicine : critère de différenciation......................2,0 g
- citrate de fer III et d'ammonium révélateur d'H2S..........1,5 g
- sels biliaires : inhibiteur................................9,0 g
- fuchsine acide : inhibiteur................................0,1 g
- bleu de bromothymol : indicateur de pH.....................0,065 g
- chlorure de sodium : maintien de la pression osmotique.....5,0 g
- thiosulfate de sodium : précurseur d'H2S...................5,0 g
- agar..........................................14,0 g
- pH = 7,5 ± 0,2
Préparation
Mélanger 75 g de milieu déshydraté avec un litre d’eau distillée stérile et porter à ébullition. Après refroidissement aux alentours de 50 degrés celcius, le milieu peut-être coulé en boîte ou flacons. Le milieu ne doit pas être autoclavé[1].
Lecture
Les colonies sont normalement des colonies de bacilles Gram négatif. Les colonies à centre noir sont H2S +, c'est-à-dire qu'elle produisent de l'H2S. Les colonies bleues ou vertes n'utilisent aucun des glucides du milieu. Elles sont donc saccharose et salicine et lactose négatives. La couleur bleue peut être due à l'utilisation du citrate. Les colonies jaunes utilisent un ou plusieurs des glucides. Elles sont donc saccharose et/ou lactose et/ou salicine positives. Un précipité de sels biliaires peut apparaître pour les souches acidifiantes.
- Colonies jaune saumon : E. coli, Klebsiella, Citrobacter, Enterobacter, Serratia
- Colonies jaune saumon à centre gris : P. vulgaris
- Colonies vertes à centre noir : P. mirabilis, Salmonella
- Colonies vertes ou bleuâtres : Shigella, Morganella morganii, Providencia
- Colonies bleuâtres oxydase+ : Pseudomonas
Notes et références
Voir aussi
Liens externes
- Portail de la microbiologie